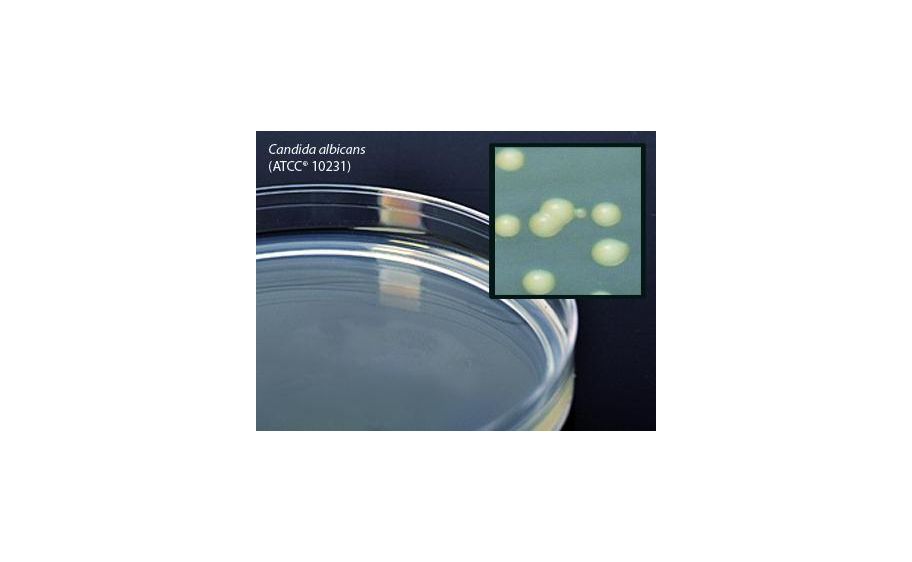
main product photo

Need Help?
800-229-7252

MEDIUM TSA PLATED W/O LABEL 23ML PK10
1
/
PK
Lead Time
12 Day(s)
SKU
VWR89407-336-PK
MFRPN
G62
MEDIUM TSA PLATED W/O LABEL 23ML PK10
TSA w/Olabel 23Ml Plate 10Pk Tryptic Soy Agar (TSA) (withoUt plate label, orientation tabs, and logo), 23ml fill, 15x100ml plate, order by the package of 10, by Hardy Diagnostics
| Manufacturer | Hardy Diagnostics |
|---|---|
| MFRPN | G62 |
| Lead Time | 12 Day(s) |
| UNSPSC Code | 12000000 |
Write Your Own Review